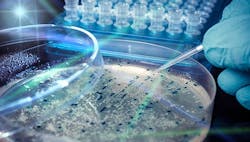
1660317500112 Upcycleecoli 1660317500112 Upcycleecoli

A one-pot process using genetically engineered bacteria converts terephthalic acid into vanillin, report its developers at the University of Edinburgh, Scotland. The scientists say this is the first example of using a biological system to upcycle plastic waste into a valuable industrial chemical.
Besides its role as a flavoring, vanillin finds use in cosmetics, herbicides, anti-foaming agents and cleaning products. Global demand reportedly approaches 40,000 t/y; Grand View Research, San Francisco, predicts the market will reach $724.5 million by 2025.
The one-pot reaction is carried out in E. coli bacteria and occurs at room temperature and pH 5.5–7 in aqueous media. It requires no additional cofactors or reagents, and generates no hazardous waste. Current conversions exceed 79%. More details appear in an article in a recent issue of Green Chemistry.
Temperature, cell permeabilization and in-situ product removal are key factors in optimizing the process, notes principal investigator Stephen Wallace. “We’re currently investigating the reasons why these factors were so successful with the aim of trying to improve them further. We’re also looking into biological methods to increase flux through the pathway by engineering the cell membrane,” he says.
Wallace and his team in Edinburgh’s Department of Biological Sciences also are looking to intensify the process further using strain engineering and by extending the pathway to other metabolites.
“Many of the intermediates en route to vanillin from terephthalic acid are central metabolites that are commonly used in many biosynthetic pathways to other useful industrial molecules. The target compounds we are now focusing on are used in the food/flavoring and pharmaceutical industries. This is really just the beginning for us,” he adds.
Chemical engineering issues such as downstream processing will pose their own challenges when the team gets to that point, Wallace believes.
Even so, the work already has attracted a great deal of interest from industry. “We are currently seeking further investment with them in the form of grants to conduct follow-on, scale-up studies later this year,” he reveals.
One outstanding issue is whether the vanillin produced in this way is fit for human consumption. “The regulatory requirements for human consumption are very complex. However, when you consider that 85% of vanillin that is manufactured today is derived from crude oil — specifically phenol — I’m optimistic that a bio-based approach from PET could meet these same requirements in the future,” Wallace concludes.
About the Author
Seán Ottewell
Editor-at-Large
Seán Ottewell is a freelance editor based in Ireland. He has an impressive background in the chemical industry. After earning his degree in biochemistry at Warwick University, UK, he earned his master's in radiation biochemistry from the University of London. His first job out of school was with the UK Ministry of Agriculture, Fisheries and Food, London, where he served as scientific officer with the food science radiation unit.
From there he entered the world of publishing. In 1990, he was the assistant editor of The Chemical Engineer, later moving on to the chief editor's position. Since 1998, he has been a regular contributor to European Process Engineer, European Chemical Engineer, International Oil & Gas Engineer, European Food Scientist, EuroLAB, International Power Engineer, published by Setform Limited, London, UK.
Chemical Processing has been proud to call Ottewell Editor at Large since 2007.
He and his family run a holiday cottage in the small village of Bracklagh in East Mayo. He also fancies himself an alpaca farmer.